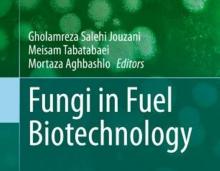

Tehran sanctions high-ranking US officials for their role in terrorism, anti-Iran measures

Tehran, Jan 19, IRNA – The spokesman of the Ministry of Foreign Affairs announced on Tuesday that Iran has sanctioned several US officials for having a role in the acts of terror and anti-human mea